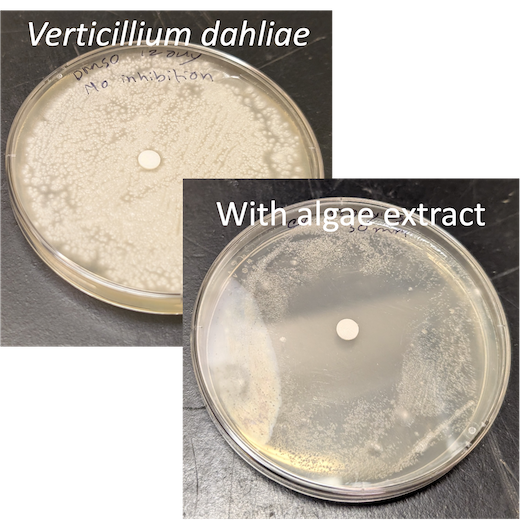

ongen R&D
Our work includes:
- mitigation of large and small scale off-gas CO2
- microalgal waste remediation and recovery of critical minerals
- bioprospecting for commercially valuable natural bioproducts for:
- disease fighting antibacterial, anticancer and antiviral agents
- antifungal agents to protect crops such as barley, vines and hops
- health beneficial antioxidants and omega3's
- nutrition enhancement of organic waste products
- biofuels
- low-cost photocatalytic systems to protect drinking water for remote communities and households
- capture and repurposing on-site industrial waste energy
- life-cycle assessment (LCA) to analyze the impact of new products and new practices
- productivity and environmental impacts from using battery electric vehicles
can be found by scrolling down.